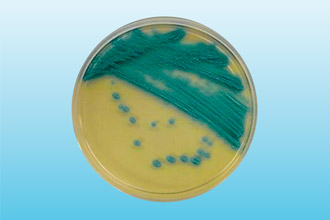
image

Воспаление трахеи может быть обусловлено аллергическими реакциями или инфекцией. Бактериальный, аллергический, грибковый и вирусный трахеит имеют между собой принципиальные отличия. В частности местные проявления, характер кашля и вероятные осложнения определяются.
Температура, приступы кашля, недомогание и жжение в горле – основные проявления трахеита любой этиологии. Точно определить возбудителя инфекции можно только по результатам микробиологического исследования, ларинготрахеоскопии и рентгенографии легких. Методы лечения зависят от разновидности заболевания, выраженности симптомов воспаления, сопутствующих заболеваний и осложнений.

Воспаление органов дыхания возникает в случае проникновения инфекционных агентов и аллергенов в респираторный тракт. Стоит отметить, что большинство возбудителей ЛОР-патологии малоустойчивы во внешней среде, поэтому заражение чаще происходит при контакте с носителем инфекции. К факторам, провоцирующим воспаление трахеи, относят:
- искривление носовой перегородки;
- обострение хронических болезней;
- вторичные иммунодефициты;
- вдыхание табачного дыма;
- запыленность воздуха;
- склонность к аллергическим реакциям;
- гиповитаминоз и железодефицитную анемию;
- перегрев и переохлаждение.
Трахеиту больше подвержены люди, страдающие сахарным диабетом, туберкулезом, сердечной недостаточностью и аденоидитом.
Появлению инфекционного воспаления благоприятствуют застойные явления в носоглотке. Поэтому хронический насморк, аденоиды, сфеноидит и постназальное затекание слизи увеличивает риск развития инфекции в нижних отделах респираторного тракта.
В отоларингологии выделяют несколько форм респираторного заболевания: аллергическое, инфекционное и инфекционно-аллергическое. Наибольшую опасность для детей и взрослых представляет инфекционно-аллергическое воспаление трахеи. В процессе развития болезни происходит сильное воспаление и отек тканей, поэтому в патологический процесс часто вовлекается трахея. В связи с этим у пациента может возникнуть ложный круп, характеризующийся приступами удушья.
В зависимости от возбудителя инфекции, выделяют следующие типы септического воспаления трахеи:
- бактериальное – провоцируется болезнетворными микробами (стрептококк, стафилококк);
- вирусное – вызывается патогенными вирусами (коронавирус, аденовирус);
- вирусно-бактериальное – воспаление провоцирует сразу несколько вирусных и бактериальных патогенов.

Затянувшийся, т.е. хронический трахеит влечет за собой патологические изменения в тканях. В местах воспаления формируются фиброзные спайки, которые не рассасываются даже после лечения. Симптомы вялотекущего воспаления выражены слабо. В дневное время кашель практически не беспокоит и обостряется либо перед сном, либо после пробуждения.
Вирусный трахеит – высококонтагиозное заболевание, которое может передаваться воздушно-капельным путем. Воспаление трахеи провоцируется неспецифическими инфекционными агентами, поэтому даже в случае заражения другого человека могут развиться смежные заболевания, к примеру, грипп, ларингит или фарингит. К самым распространенным возбудителям инфекции относят:
- аденовирусы;
- вирус парагриппа;
- коронавирусы;
- риновирусы;
- энтеровирусы.
Зачастую развитию трахеита сопутствуют другие вирусные заболевания – простуда, грипп, бронхит, скарлатина, пневмония, ветряная оспа и т.д. При прогрессировании инфекции патогены проникают в нижние воздухоносные пути и поражают слизистую трахеи. Как правило, при остром вирусном воспалении тканей осложнения не возникают. Но если заболевание не лечить, к вирусам может присоединиться микробная флора. Трахеиты смешанного типа лечатся сложнее, поэтому рекомендуется обращаться к специалисту до существенно ухудшения самочувствия.
К числу типичных проявлений вирусного поражения трахеи относят сухой кашель, головные боли, покраснение слизистой горла, повышение температуры, слабость и отсутствие аппетита. При осложненном трахеите в очагах поражения могут возникнуть гнойники, свидетельствующие о размножении гноеродных микробов.
Гнойное воспаление трахеи может стать причиной абсцесса в дыхательных путях, которое повышает риск развития системного воспаления, т.е. сепсиса.
ЛОР-заболевание бактериального генеза вызывается преимущественно кокками – золотистым стафилококком, пневмококком, менингококком и т.д. Во время размножения болезнетворные микробы выделяют токсические вещества, вследствие чего у пациента появляются симптомы сильной интоксикации:
- боль в суставах и мышцах;
- тошнота;
- отсутствие аппетита;
- боли в животе;
- проблемы со стулом.
Бактериальный трахеит потенциально более опасен, чем вирусное заболевание. Дело в том, что бактерии провоцируют гнойное воспаление трахеи, вследствие чего возникает риск развития заглоточного абсцесса. Кроме того, у больных сильно повышается температура (вплоть до 40°C), вследствие чего наступает обезвоживание. У маленьких детей могут возникнуть фебрильные судороги и галлюцинации.
При распространении инфекции часто поражаются хрящевые ткани, вследствие чего развивается эпиглоттит и ложный круп.

- болезненность и увеличение лимфоузлов;
- лихорадку и усиленное потоотделение;
- влажный спастический кашель;
- белый налет на стенках гортаноглотки;
- сильные боли в горле при глотании;
- увеличение и покраснение небных миндалин;
- затрудненное дыхание;
- обильное отделение мокроты с гноем.
Из-за отека слизистых возникает «свистящее» дыхание, которое называют стридором. Со временем больные жалуются на недостаток кислорода и головокружение. При сильном сужении гортани может потребоваться экстренная помощь и интубация трахеи.
Трахеомикоз (грибковый трахеит) – заболевание, которое провоцируется плесневыми и дрожжеподобными грибками. Возбудителями инфекции выступают аспергиллы, актиномицеты или грибки рода Candida. Отличительная черта грибкового воспаления – наличие творожистого налета на стенках трахеи.
Как и в случае с вирусным заболеванием, трахеомикоз зачастую развивается на фоне других болезней – грибкового тонзиллита (тонзилломикоз) или фарингита (фарингомикоз). Наименее агрессивной считается кандидозная флора, которая довольно просто ликвидируется с помощью антимикотиков. Аспергиллез и актиномикоз провоцируют сильную интоксикацию организма и отек трахеи, вследствие чего проявляются симптомы дыхательной недостаточности.
При актиномикозе в трахее могут образовываться свищи, которые можно ликвидировать только хирургическим путем.
Как правило, при грибковом поражении органов дыхания сильные боли в горле не возникают до тех пор, пока слизистая не покроется изъявлениями. Патогены очень быстро размножаются посредством спор, поэтому в воспаление могут вовлекаться бронхи и глотка. Это может стать причиной бронхо- и ларингоспазмов, которые в ряде случаев приводят к острой асфиксии.
К проявлениям трахеита микотического генеза относят:
- приступообразный кашель;
- аллергический насморк;
- затрудненное дыхание;
- жжение и зуд в гортани;
- субфебрилитет (невысокая температура).
При своевременном прохождении антимикотической терапии грибковую флору можно ликвидировать в течение 5-6 дней. Однако при развитии актиномикоза инфекция глубоко проникает в ткани, поэтому для ее ликвидации необходимо использовать противогрибковые средства системного действия.
Несмотря на практическое отсутствие дискомфорта в горле, лечить хроническое воспаление необходимо. Со временем в тканях наблюдаются патологические изменения, в связи с этим у пациентов диагностируют одну из двух форм вялотекущего трахеита:
- гипертрофический – характеризуется сильным утолщением слизистой и влажным кашлем;
- атрофический – в слизистой происходят дистрофические изменения, вследствие чего мерцательный эпителий истончается, а в некоторых местах покрывается корочками.
При продолжительной ремиссии внешние проявления болезни практически отсутствуют. Кашель может проявляться только вечером или сразу же после пробуждения. Температура и симптомы интоксикации практически не беспокоят пациентов. Но в случае снижения иммунной защиты микробы быстро размножаются, вследствие чего возникает обострение трахеита. При рецидивах признаки болезни идентичны тем, которые проявляются при остром воспалении трахеи.
После тщательного обследования пациента лечащий врач назначает соотвествующее лечение. Продолжительность терапии и типы используемых средств определяются природой возбудителя ЛОР-заболевания. Вирусы можно уничтожить противовирусными средствами, грибки – антимикотиками, а микробы – антибиотиками.
Помимо этиотропных средств, уничтожающих инфекцию, используют лекарства симптоматического действия. Они купируют кашель, уменьшают отечность, способствуют заживлению слизистых и уменьшению выраженности признаков интоксикации. Чаще всего в схему терапии входят следующие лекарства:
- противовирусные – «Арбидол», «Кагоцел»;
- жаропонижающие – «Парацетамол», «Нурофен»;
- отхаркивающие – «Амбробене», «Алекс Плюс»;
- антигистаминные – «Диазолин», «Зиртек»;
- антибиотики – «Амоксиклав», «Цефтриаксон»;
- антимикотики – «Хэпилор», «Леворин»;
Чем лечить гнойный трахеит? Гнойные формы ЛОР-заболевания провоцируются гноеродными микробами, поэтому их лечат антибиотиками цефалоспоринового, макролидного и пенициллинового ряда.
Источники: medscape.com, health.harvard.edu, medicalnewstoday.com.
Мнение врачей:
Трахеит – это воспалительное заболевание трахеи, которое может иметь различные разновидности. Врачи отмечают, что существует острая и хроническая форма трахеита. Острая форма обычно вызвана вирусами или бактериями и характеризуется резким началом симптомов, таких как кашель, затрудненное дыхание и боль в горле. Хроническая форма трахеита может развиваться под воздействием раздражающих факторов, таких как курение или загрязненный воздух, и проявляется более длительными и менее выраженными симптомами. Важно обратиться к врачу при первых признаках трахеита для точного диагноза и назначения соответствующего лечения.
Опыт других людей
Разновидности трахеита вызывают разные отзывы у людей. Одни считают, что острый трахеит проявляется резкой болью в горле, затрудненным дыханием и кашлем. Другие отмечают, что хронический трахеит проходит более замедленно, сопровождаясь постоянным раздражением и чувством сухости в горле. Некоторые утверждают, что лечение трахеита требует терпения и строгого соблюдения назначений врача, в то время как другие считают, что народные средства также могут помочь в борьбе с этим заболеванием. В целом, мнения о разновидностях трахеита различны, но все согласны в том, что важно своевременно обращаться к специалисту и следовать его рекомендациям.
https://youtube.com/watch?v=X_67sOT2GRE
Частые вопросы
Какие причины вызывают трахеит?
Трахеит может быть вызван вирусными, бактериальными и грибковыми инфекциями, а также воздействием раздражающих веществ, таких как табачный дым или пыль.
Каковы симптомы трахеита?
Симптомы трахеита включают кашель (сухой или влажный), осиплость голоса, боль в горле и боль в груди при кашле.
Полезные советы
СОВЕТ №1
При первых признаках трахеита, таких как кашель, затрудненное дыхание, боль в горле, обязательно обратитесь к врачу для точного диагноза и назначения лечения.
СОВЕТ №2
Избегайте курения и контакта с дымом, так как это может усугубить симптомы трахеита и замедлить процесс выздоровления.
СОВЕТ №3
Следите за влажностью в помещении, используйте увлажнители воздуха, чтобы смягчить раздражение слизистой оболочки горла и трахеи.